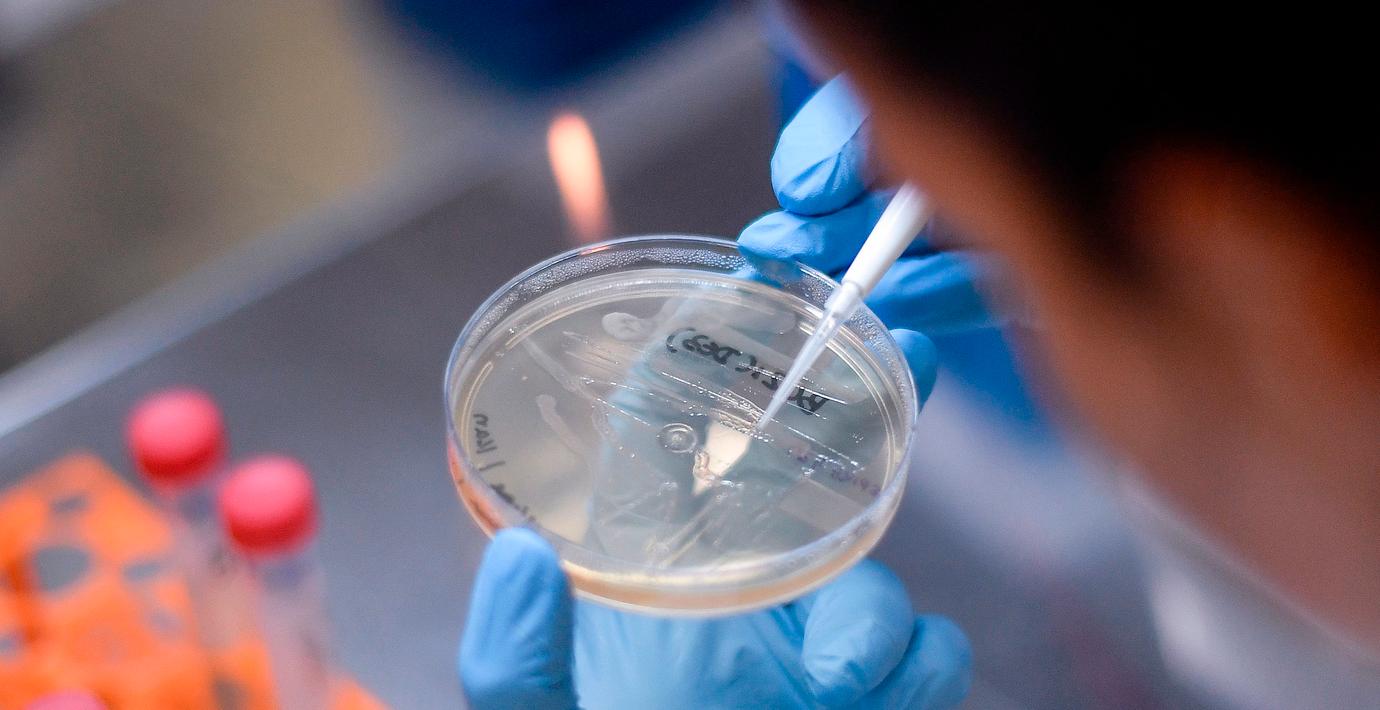

Läkemedelsjättens mål: En miljard vaccin för 2021
Läkemedelsjätten Johnson & Johnson hoppas kunna skala upp produktionen av ett coronavaccin i år, säger företagets forskningschef till CNN.
– Vi startar kliniska tester i september och har förhoppningsvis data mot slutet av året, säger Paul Stoffels till kanalen.
Stoffels tillägger att målsättningen är uppemot en miljard vaccin under nästa år. Han säger också att ett vaccin kommer att vara klart i år, men att det kommer vara upp till myndigheterna när det kan användas.
Läs mer
Omni är politiskt obundna och oberoende. Vi strävar efter att ge fler perspektiv på nyheterna. Har du frågor eller synpunkter kring vår rapportering? Kontakta redaktionen



